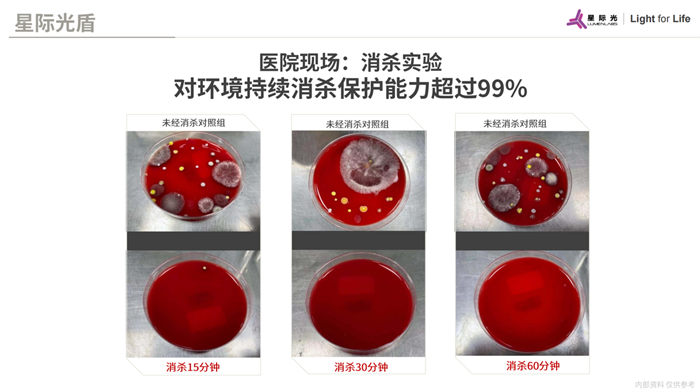

星際光(上海)實業有限公司
2023-02-24 來源:本站原創
九一无码视频一区二区三区|
亚洲中文字幕你懂的吗|
日韩成人三级电影视频网|
中文字幕,精品在线|
看黄片免费看视频全过程|
婷婷视频一区二区三区|
久久久成年人免费黄片|
日本午夜高清免费视频|
国产一区不卡自拍视频在线观看|
人人爱人人插人人射|
国产精品第一页在线|
日韩一区二区在线视频2|
欧美一区二区三区一|
高级亚洲成人色情网站|
日韩久久精品五月综合|
综合久久av一区二区|
熟女怡红院一区二区|
从后面抱住使劲日逼视频|
亚洲宅男av一区二区三区|
狠狠精品久久久无码中文字幕|
婷婷伊人五月天综合网|
小黄片免费在线播放观看|
久久老熟女一区二区蜜桃|
天天插天天透大香蕉伊人|
啊啊啊不要我受不了了|
最近中文字幕高mv在线|
巨乳人妻视频中文字幕|
亚洲成色一区二区三区|
欧美日韩在线视频你懂的|
国产久久久中文字幕|
亚洲免费一区二区视频|
av中文字幕高清片|
色呦呦av在线观看|
A片无码高清在线观看免费|
在线精品日韩亚洲欧一二三区|
久久久噜噜噜久久美女厕所偷拍
|
国产偷国产偷亚洲视频|
中文字幕在线播放av|
亚洲一区二区丝袜美腿人妻|
你懂的小视频在线观看|
日中文字幕成人在线视频|
天天舔天天插天天干|
蜜臀在线一区二区三区|
91精品国产刺激国语对白|
中文字幕久久久乱码|
欧美人妻羞羞一区二区三区|
午夜亚洲AV永久无码精品|
亚洲男人天堂一区二区在线观看|
亚洲国产二区三区天堂|
亚洲五月六月丁香激情在线观看|
中文字幕第一页欧美|
黑色的大鸡巴视频|
亚洲成色一区二区三区|
色97在线观看视频|
丰满人妻一区二区三区站长|
国产又大又长又租又大的|
快来插我的骚逼我好想要视频|
99热毛片中文字幕|
中文字幕乱码在线日韩|
无遮挡在线观看视频国产欧洲|
日韩人妻大奶子生活片|
国产精品不卡在线观看的a站|
欧美日本一级特黄大片|
大胆gogo人体无码免费视频|
日本一二三区不卡在线|
fc2国产精品视频|
长泽雅美av一区二区三区|
国产欧美一区二区久久久|
欧美激情在线观看第二页|
国产在线小视频免费|
亚洲欧洲日韩综合另类|
中文字幕永久精品国产|
中文字幕在线观看视频|
亚洲男人的天堂你懂的|
国产精品视频 射精|
成人免费全程视频在线观看|
91秦先生琪琪在线|
国产女主播成人av|
91大神在线精品视频一区|
91精品中文字幕在线观看|
国产精品第一页在线|
免费在线观看的黄片视频在线观看|
偷拍熟女精彩对白91九色|
国产又粗又爽免费视频|
久久久久久黄色精品视频|
久久婷婷六月综合综|
日韩大片一区二区在线观看
|
99国产欧美久久精品|
美女13性爱视频鸡巴插进逼里|
最近中文字幕高mv在线|
啊啊啊啊草逼视频|
亚洲日本中文字幕在线四区|
亚洲图色欧洲图色欧洲|
国产农村妇女三级全黄在线阅读
|
亚洲av少妇高潮流白浆在线|
国产h在线视频观看|
激情综合婷婷六月天|
国产亚洲精品福利在线无卡一|
久久一卡二卡亚洲精品|
日韩美女精品视频在线观看网站
|
久久热精品一区二区三区|
91成年人免费视频|
欧美一区二区三区久|
亚洲国产精品欧美日韩|
久久精品久久精品久久|
色淫淫一区二区三区|
亚洲成人男人的天堂|
国产熟女白浆精品一区二区|
亚洲伊人久久综合影院
|
毛片无码高潮喷液视频狠|
久久亚洲毛片中文字幕|
日韩美女精品视频在线观看网站
|
国产一区二三区好的|
精品久久久在线观看|
91自拍视频在线看|
男人的天堂激情免费|
国产一区二区三区免费视频网站|
日韩中文字幕性视频|
亚洲日本国产精品高清|
久久久久久免费系列91|
国产精品一区二区三区四区久久|
入口一区二区三区国产|
国产午夜精工厂av|
国语自产偷拍精品视频偷95|
五月婷婷丁香蕉视频在线|
欧美日韩一区二区久久久久久|
久久久999国产在线|
51国产精品鸡吧操逼|
国产精品AV在线|
亚州石原莉奈一区二区在线观看|
久久人妻无码一区二区e|
中文字幕丰满乱子无码视频|
精品久久久在线观看|
日韩午夜福利无码专区A|
久久99精品色婷婷|
国内精品一区二区三区在线视频|
婷婷六月激情综合一区|
人妻沦为恶霸性玩物|
91秘一区二区三区四区|
美女午夜福利视频一区二区|
北条麻妃人妻隔壁邻居的秘密|
午夜福利在线观看国产精品|
69精品人人人妻人人玩天堂|
中文字幕精品一区推荐|
黑人大吊V荷兰极品|
中文字幕三级在线视频|
五月天 开心 激情|
国产精品久久电影网站红桃视频|
大香蕉国产免费av|
欧美成人三级国产精品电影|
久久超级碰碰人妻人人妻|
久久久成年人免费黄片|
久久婷五月天色综合久久|
国产 欧美 一区 二区|
色综合久久精品中文字幕|
黑人巨大精品欧美一区二|
深夜福利视频网站在线|
中文字幕一区二区肥臀人妻|
日韩精品色综合av|
欧美日韩国产中文另类|
大鸡吧用力操我啊视频|
婷婷激情五月天小说网|
久久精品在这里999|
美女被大鸡巴干了视频网站|
910婷婷激情五月伦理片|
久久国产亚洲av高清|
97久久久久久国产精品|
一区二区三区嗯嗯啊啊|
肥熟女巨臀一区二区三区|
久久99综合久久久久|
人妻免费高清视频一区二区三区|
91久久久精品黑人|
久久热这里只有精品网|
a黄片在线视频免费播放|
日韩中文字幕一区二区高清在线|
亚洲黄色一区二区三区四区|
成人区人妻精品一|
色综合伊人色综合网|
伊人久久网伊人网综合网|
亚洲午夜电影久久久久|
经典三级开心五月天|
久久国产亚洲av高清|
亚洲欧美日韩国产重口一区二区|
哺乳人妻奶头奶水流出|
爱情岛论坛亚洲永久自拍|
风流老熟女一区二区三区91|
欧美一区二区三区四区动漫|
亚洲国产精品欧美日韩|
欧美日韩影音先锋第一页|
日韩精品一区二区三级电影|
久久精品人妻少妇一区二区|
亚洲精品未满十八禁止观看|
艳骚姥胡美欧胖妇在线播放视频|
蜜桃视频网站在线观看|
麻豆黄色一级大片儿|
麻豆国产av免费观看|
日韩欧美中文字幕一区二区三区|
好吊操视频这里只有精|
日韩av在线天堂网|
色九九色综合色蚂蚁|
美女女很黄的免费的视频|
久久婷婷六月综合综|
国产精品成人va在线观|
色哟哟免费观看网站|
91精品国产高清一区二区三蜜臀|
欧美日韩在线视频你懂的|
韩国中出人妇免费观看|
亚洲黄色电影四区欧洲|
吃老师的黑鲍鱼喷白浆给我吃|
中文字幕乱码亚洲无线|
亚洲嫩模喷白浆在线观看自拍|
丰满人妻熟妇又伦精品软件|
人妻沦为恶霸性玩物|
国产成?人?综合?亚洲网站|
亚洲乱熟乱熟女一区二区|
高级亚洲成人色情网站|
亚洲 自拍 偷拍 一区 二区|
人妻夜夜爽天天爽爽|
日韩午夜福利无码专区A|
欧美一区二区三区精选|
av男人的天堂在线一区二区|
老司机啪啪啪啪拍|
日韩av,av在线|
国产欧美另类第一页|
国产一区二区三区高潮|
av电影嫩草久久精品|
国产亚洲精品久久精品69|
综合欧美一区 二区 三区
|
国产乱子伦视频三区|
美女洗澡偷拍一区二区|
国产精品久久久爽爽爽麻豆色哟哟|
久久欧美三级福利视频|
成人在线午夜你懂的视频|
艳骚姥胡美欧胖妇在线播放视频
|
亚洲一区二区三区四区少妇|
欧美式一区二区三区|
亚洲宅男av一区二区三区|
国产亚洲精品拍拍视频|
亚洲久久精一区久久久|
国产av中文字幕,|
国内精品一区二区三区在线视频
|
男人操女人操出白浆的视频|
大香蕉日韩在线观看视频网站大全|
国产码一区二区三区|
国产精品不卡在线观看的a站|
美女洗澡偷拍一区二区|
久久这里只有精品小视频|
大鸡巴操逼骚逼护士|
小黄片免费在线播放观看|
51男人天堂久久久|
国产精品AV在线|
久久五月天亚洲综合|
国产精品久久久久久久精品av|
蜜桃一卡二卡在线观看|
久久高清免费福利视频|
丁香激情六月天婷婷|
婷婷五月开心五月久久|
国产av自拍偷拍网|
婷婷婷婷婷婷婷婷色图|
久久午夜亚洲欧美精品|
国产精品伦一区二区三级视频
|
人人爽人人妻人人片av|
亚洲成a人片在线电影|
中文字幕在线综合视频|
97操自拍视频在线|
亚洲一区 二区 精品|
中文字幕不卡视频91|
中文字幕精品一区推荐|
欧美日韩国产高清一区二区三区|
美国一区二区免费视频|
欧美日韩亚洲国产综合在线观看|
国内偷拍视频免费久久|
台湾佬娱乐网22更新|
久久这里只有精品蜜臀|
欧美一区二区三区在|
国产精品黄片久久久久|
中文字幕丰满人妻熟女|
欧美日韩国产免费视频|
中文字幕,精品在线|
好吊视频一区,二区|
久久99热这里只有精品|
中文字幕亚洲精品人妻|
欧美一区二区三区四区动漫|
黑人性黄色大片免费看|
国产日本欧美一区二区在线|
亚洲最色在线视频观看|
操欧美肥胖女人大逼|
亚洲 自拍 偷拍 一区 二区|
透处女的免费视频|
国产日本欧美一区二区在线|
亚洲一区二区一区二区免费视频|
黑色的大鸡巴视频|
日本熟女大全中文字幕|
亚洲成人中文字幕电影在线观看|
婷婷六月激情综合一区|
亚洲精品av中文字幕|
99热国产只有精品|
国产激情片一区二区三区|
99热国产在线播放|
狠狠干狠狠操狠狠狠玩|
黄色av啊啊啊av一区久久久|
亚洲综合成人丁香婷婷六月|
亚洲男人天堂 av|
亚州石原莉奈一区二区在线观看|
亚洲av日韩av卡二|
99久热只有精品视频免费看|
日韩一区二区黄色网|
欧美日韩综合色综合|
91久久精品一级片|
老太太与黑人大鸡吧|
亚洲精品视频在线国产|
亚洲精品日本久久一区二区三区|
亚洲五月天在线观看|
五月婷婷高清在线观看|
99re在线视频一区|
五月天色婷婷丁香六月|
国产手机精品一区|
久久久亚洲蜜桃精品|
国产精品黄色在线观看网站|
国产日韩欧美高清一区二区|
国产精品,在线观看|
美味人妻2016韩国电影|
国产极品粉嫩福利姬萌白酱|
老熟女偷拍一区二区|
人妻欲求不满av中文字幕一区|
亚洲成人午夜精品av|
日韩美女午夜免费视频|
欧美黑人精品在线免费观看视频
|
久久亚洲道色宗和久久|
台湾佬娱乐网22更新|
不卡av免费在线网址|
成人精品久久久国产|
在办公室被c到高潮小雪|
日韩欧美亚洲理论片|
日本黄网站色大片免费观看|
国产亚洲精品美女久久不能|
天天舔天天插天天干|
中文字幕丰满乱子无码视频|
国产电影精品久久久久久|
亚洲色图蜜桃中文字幕综合|
最近91中文字幕二区|
亚洲色图欧美在线视频|
爽歪歪视频在线观看|
中文字幕精品亚洲天堂|
99精品国自产在线|
精品国产欧美精品v|
青娱乐一亚洲高清视频在线观看|
人妻人人澡人人添人人爽|
性感美女喷白浆做爱91|
男生操白丝袜美女逼逼|
故意挺着两个大骚奶头视频|
中文字幕乱码亚洲精|
用大鸡巴操美女屁股视频|
五月婷婷在线播放一区|
六七十路熟女交尾五十路播放|
亚洲日本中文字幕在线四区|
嗯疼轻点视频免费观看视频|
操老骚女人逼视频|
国产久久久久久18|
人妻被黑人上司持续侵犯|
操逼看片视频国产91|
精品一卡二卡三卡四卡兔|
久久亚洲精品视频|
欧美成人区精品一区二区婷婷|
国产久久99精品热|
91秦先生琪琪在线|
91久久久视频在线观看|
97国产在线一区二区精品|
一本之道久久成人综合|
亚洲av三级黄色片|
国产亚洲精品美女久久不能|
婷婷六月激情综合一区|
中文字幕欧美激情一区|
操女生下面流白浆免费视频|
丰满老熟女一区二区|
国产精品毛片久久久久|
欧美精品亚洲精品一区|
精品国产视频免费看|
香蕉亚洲视频在线观看|
一区二区三区在线免费|
日本野外强奷在线播放va|
在线播放亚洲欧美一区二区|
蜜桃久久久久久av|
四虎影视国产精品免费久久|
日韩av免费观看一区日日骚|
又爽又黄又无遮掩的免费视频|
用大鸡巴操美女屁股视频|
中文字幕成人免费视频|
国产盗摄精品一区二区三区|
操骚逼黑丝鸡巴逼水内射|
婷婷激情四射综合网|
大屌骚逼视频初恋|
日本高清一区二区在线免费|
成人99一区二区激情免费看|
男人操妇女大红肉p|
中国亲子伦理一区二区|
亚洲AV无码偷拍在线观看|
蜜桃一卡二卡在线观看|
日韩不卡的av在线|
天天av天天操夜夜干|
大香蕉久久一本网站|
国产九九九久久久久|
麻豆蜜桃精品久久久|
欧美大黑吊干中国女人|
大鸡巴操大屁股美女网页|
精品一区二区色呦呦|
圈套沦胯下的新婚人妻|
中文字幕乱码视频伊人|
国产一区视频你懂得|
久久久久人妻无码一区三区|
黄色av啊啊啊av一区久久久|
粗大的内捧猛烈进出爽女视频|
99久久国产亚洲精品美女|
日韩美女午夜免费视频|
一区二区三区,视频|
69精品人人人妻人人玩天堂|
激激激激激激激激激激激情综合网
|
人人爱人人插人人射|
99热国产这里只有金品|
女生黑骚逼被操高潮视频|
欧美一区二区三区爽大粗|
中文字幕精品一区推荐|
美女嫩穴被大鸡吧抽插视频|
大香蕉久久一本网站|
国产黄色av片在线观看|
欧美日韩国产高清一区二区三区|
一区二区三区,视频|
亚洲欧洲av人一区二区|
操逼高清免费观看|
中文字幕,日本在线|
国产一区二区黄页网站|
四虎视频国产精品免费入口|
a天堂中文在线字幕|
亚洲肥婆一区二区三区|
久久国产亚洲精品嫩草|
亚洲无码一区二区三区91
|
大鸡巴操逼啊啊啊啊爽|
欧美日韩精品福利欧美|
91精品蜜桃一区二区三区|
国产精品不卡在线观看的a站
|
蜜芽忘忧草三区老狼大豆|
国产精品黄色免费网站|
尻日本女人的大逼|
日本老熟妇一区二区|
日韩一区二区黄色网|
国产亚洲日本精品一区二区
|
久久人妻精品免费二区|
最新东京热n日韩专区|
国语对白三级在线观看|
国产成视频在线观看|
一级做a在线播放免费|
插入女人逼逼视频|
正在播放国产三级自拍|
国产伦精品二区一区二区三区|
国产精品午夜久久久久|
国语自产偷拍精品视频偷95|
精品国产欧美精品v|
我不卡在线观看高清视频|
国产精品视频偷拍自拍|
日韩久久精品五月综合|
大黑逼大黑逼大乱交|
口述我丰满老师的性事|
亚洲五月天在线观看|
中文字幕亚洲精品人妻|
亚洲天堂丰满人妻av|
亚欧美日乱码视频在线观看|
91免费看精品国产|
亚洲成人中文字幕电影在线观看|
日本黄色国产草逼视频|
免费黄片精品一区二区|
国产av一区二区三区中文|
男人的天堂VA在线无码|
亚洲欧美激情国产一区二区|
国产不卡av中文字幕|
妖精成人无码a区在线视频|
女优中文字幕在线视频|
亚洲人 女同志 狂欢|
在线观看欧美日韩黄片|
精品久久久久久精品中文字幕无码|
五月婷婷激情综合少妇|
国产精品视频在视频|
91大神在线观看一区二区三区|
一区二区三四区av|
国产国产在线播放你懂的|
一区二区三区日韩免费观看97|
日韩欧美性色生活片|
高潮按摩久久久久久av免费|
国产精品视频九九九|
91色视频东北熟女|
国产精品波多野吉衣av|
中文字幕久久亚洲精品|
99国产欧美久久精品|
亚洲人成无码综合网|
22精品一区二区三|
麻逼好想要鸡巴日|
日韩精品 中文字幕|
亚洲精品日韩精品日韩专区一|
人人舔天天操人人射|
久久久精品人妻中出|
久久久久久久久熟女av|
中文字幕精品人妻av|
黑丝袜美女被操哭了|
亚洲宅男av一区二区三区|
av中文字幕18p|
久久婷婷激情综合色综合俺也去|
人人精品亚洲永久免费精品|
日韩av免费观看一区日日骚|
日本在线视频一区二区三区|
色婷婷国产综合激情看片|
好吊视频一区,二区|
国产一区二区在线综合在线|
亚洲av免费在线网站|
操老骚女人逼视频|
欧美成人区精品一区二区婷婷|
国产日韩精品欧美综合区|
被前后进入的熟妇羞辱
|
骚穴大鸡巴在线视频|
啊啊啊好爽使劲插视频|
大香蕉六月丁香婷婷蜜桃|
亚洲一二三区MV中文字幕|
黄色激情一区二区三区|
中文字幕免费视频|
国产精品成人va在线观|
中文字幕不卡视频91|
国内精品久久国产|
美国大吊操 视频直播间|
黄色亚洲精品在线免费观看|
日韩人妻大奶子生活片|
天天舔天天插天天干|
插入女人逼逼视频|
狠狠精品久久久无码中文字幕|
中文字幕成人免费视频|
婷婷综合中文字幕在线|
国产一级特黄aaa片做|
欧美破处视频在线|
91成人免费短视频|
韩国日本国产三级视频|
玖玖热国产在线观看|
亚洲综合在线视频在线播放|
日本精品一区二区三区乱码|
久久这里只有精品小视频|
亚洲成人黄色av一区二区|
国产盗摄精品一区二区三区|
伊人久久大香蕉在线|
亚洲一区二区三区av中文字幕|
韩日精品一区二区三区|
小鸡鸡插女人视频|
婷婷五月花亚洲一区在线观看|
国产老熟女视频一区|
久热手机在线视频亚洲|
曰韩无码中文字幕毛片一级|
欧美综合亚洲无女搜查官|
色呦呦av在线观看|
深爱婷婷激情五月天|
国产一区二区麻豆视频|
国产又粗又猛又黄又爽|
日本精品女同免费观看|
日本性爱无遮挡视频|
大鸡扒插入白丝班长的小学|
青青草国产精品亚洲专区无|
丰满人妻一区二区二区|
精品人妻一区二区三区码|
国产69精品久久99不卡|
国产精品久久久九九九|
国产精品卡一卡二卡三卡四|
黑人大鸡吧操嫩逼|
中文字幕人妻森泽佳奈|
嗯嗯啊啊啊成人在线观看视频|
欧美激情丝袜一区二区三区|
日韩三级妈妈的朋友|
国产伦精品一区二区三区免费观看
|
天天舔天天插天天干|
天天干夜夜操2017|
久久婷婷激情综合色综合俺也去|
一区二区三区白浆喷水爆乳|
精品午夜久久久久久99|
日韩有码视频在线看|
欧洲亚洲精品视频在线观看|
久久久久国产精品免费|
久久久久一区二区三区|
久久国产亚洲精品嫩草|
国产自拍av在线观看网站|
日本怡红院在线观看视频|
亚洲午夜久久久久久69|
中文字幕熟女人妻乳一区二区|
美女13性爱视频鸡巴插进逼里|
欧美日韩在线一级初|
久久久久久久久久久青青|
一区二区三精品人妻|
熟妇人妻精品猛烈进人视频|
欧美精品精品一区在线发布|
搬开逼操喷水视频|
国产老熟女视频一区|
欧美粉嫩一区二区三区婷婷|
午夜福利国产精品|
内射中文字幕免费在线观看|
91在线看福利资源|
91精品国产综合久久久久丝瓜|
亚洲色图欧美在线播放视频|
欧美一区二区三区四区动漫|
中文字幕一区三区四区|
亚洲天堂欧美天堂淫人天堂|
成人一区二区三区免费在线观看|
久久99都市激情五月|
麻豆黄色一级大片儿|
2018免费福利视频一区|
用大鸡巴操美女屁股视频|
日韩av成人社会区|
被前后进入的熟妇羞辱|
91秘一区二区三区四区|
91成年人在线观看|
好吊日视频一区二区|
青青草视频手机在线免费观看|
蜜芽忘忧草三区老狼大豆|
久久一区二区三区视频|
免费看精品黄色视频|
中文字幕人妻丝袜av|
亚洲天堂网一区二区三区四区
|
国产69色在线视频|
美女主播大奶子户外操逼尿尿|
亚洲色图蜜桃中文字幕综合|
久久久久久黄色精品视频|
欧美日韩亚洲综合久久|
精品国产视频免费看|
国产欧美日韩综合aⅴ天堂|
1区2区3区中文字幕在线|
向井蓝被黑人中出的人妻|
91精品国产91次久久福利|
久久久97成人超碰|
女人扒开尿道让男人捅|
色婷婷精品久久久久久久|
毛片免费久久蜜臀av|
一区二区三区在线免费|
亚洲伊人久久综合影院|
国产精品,在线观看|
狠狠躁日日躁夜夜躁婷婷|
日韩av免费观看一区日日骚
|
欧美日韩精品亚洲专区|
在线被黑人操虚脱|
亚洲精品97久久久|
亚洲人成在线视频观看|
又大又猛又粗国产精品|
国产麻豆久久久91|
人妻少妇偷人伦伦精品视频|
我要看国产精品毛片|
波多野结衣在线成人精品|
久久精品国产只有精品2020|
欧美日韩久久亚洲区|
久久久欧美一区二区|
日韩精品国产一二三区|
日本成人一区二区三区|
女人扒开尿道让男人捅|
久久精品在线视频观看|
国产精品午夜久久久久|
中文字幕丰满乱子无码视频
|
日韩av免费观看一区日日骚|
美女洗澡偷拍一区二区|
久热这里只有精品67|
91大神一区二区三区在线视频|
亚洲国内精品久久久|
亚洲日本国产精品高清|
日韩av在线www|
亚洲欧洲日韩综合另类|
亚洲美女国产精品久久|
五月婷婷激情综合少妇|
日本不卡手机在线视频|
欧美日韩国产一级在线|
色视频一区二区三区在线观看
|
亚洲av少妇高潮流白浆在线|
久久婷婷视频在线观看|
日韩欧美特级特黄大片|
91欧洲午夜精品久久久久|
又大又猛又粗国产精品|
黄色频xxx线观看xx|
亚洲伊甸园久久伊人久久|
精品国产视频免费看|
欧美一区二区三区二区|
在线观看蜜桃一卡二卡|
国产精品一区二区三区熟女|
欧美日本精品十八小视频|
亚洲饱满人妻视频|
亚洲高清一区二区高清|
一区二区三区日本免费在线观看|
亚欧美日乱码视频在线观看|
国产av一区二区三四区|
91在线521欧美|
国产精品视频在视频|
日韩欧美在线第一页|
日韩欧美一级黄色录像|
2020亚洲天堂网|
亚洲美女自拍偷拍视频|
日韩久久精品五月综合|
国产人妻 一区二区|
深夜福利国产一区二区|
搬开逼操喷水视频|
99久热只有精品视频免费看|
69成人精品久久久|
男人的天堂av高清|
狠狠777福利视频|
香蕉视频看一次爽一次|
在线日韩精品视频一区二区三区|
三级国产自拍在线观看|
成人专区污污污污污污网|
国产人妻少妇一区二区|
丰满老熟女一区二区|
亚洲av少妇高潮流白浆在线|
91精品国产丝袜拍国语剧情|
最新国产不卡在线视频|
97狠狠干婷婷五月天|
伊人久久综合热线大杳蕉av|
一区二区三四区av|
99国产精品久久久久久成人热|
亚洲精品视频在线国产|
国产黄色三级三级看三级|
国产精品污一区二区三区在线观看|
国产精品久久一区二区毛片|
国产亚洲精品综合一|
v影院一区二区三区自产不卡视频|
成人国产亚洲欧美日韩|
啊啊啊啊草逼视频|
久久水密桃亚洲av|
国产精品免费观在线|
久久毛片免费观看大全|
操欧美肥胖女人大逼|
国产久久久久久18|
日韩午夜福利无码专区A|
在线视频你懂得色日韩|
插逼内射苍井空建材|
国产亚洲精品美女久久不能|
亚洲精品日韩精品日韩专区一|
亚洲欧美黄片在线观看|
人人看人人在人人妻|
女人18毛片a级毛片视频|
黄色不卡的视频网站一区二区|
成人黄视频在线观看|
全裸美女在床上被男生巨大屌抽插|
舔鸡巴快感快插欧美|
熟妇人妻丰满激情视频在线看|
免费视频福利在线观看|
亚洲国内精品久久久|
中文字幕一期二期视频|
国产人妻中文欧美制服|
热99re久久精品天堂vr|
久久99热这里只有精品|
美女吃大机巴被美国人操|
亚洲天堂精品久久网站|
骚女颤抖av自拍|
91人人妻人人澡人人精品|
人妻av在线区一区二区三|
91大尺度麻豆久久|
国产精品一级毛片无精东影业|
98欧美日韩精品亚洲欧美|
国产自拍 日韩三级|
久久只有精品婷婷五月天尤
|
欧美高清成人一区二区|
制丝袜业一区二区三区|
亚洲三级一区在线观看|
欧美日本精品十八小视频|
干了个少妇水好多视频|
精品一区二区三区推荐|
亚洲婷婷中文字幕在|
黄色激情一区二区三区|
国产女主播成人av|
久久久久一区精品网|
色婷婷久久国产精品|
中国美女一级特黄大片大全久热|
久久久久久综合88_|
91精品蜜桃一区二区三区|
成人黄视频在线观看|
亚洲日韩欧美一区久久久久久久|
老师的丝袜诱惑91视频|
午夜福利在线观看国产精品|
最新av网址久久久中文字幕|
国产二区三区在线播放|
亚洲中文字幕高清观看|
久久婷婷视频在线观看|
成人国产av精品蜜桃小|
亚洲一区二区三区四区桃色|
99热国产精品re|
欧美日韩一区二区久久久久久|
国产极品av一区二区三区|
免费久久久国产精品|
91re视频免费看|
狠狠操天天干天天色|
亚洲成人黄色av一区二区|
国产av自拍偷拍网|
青青青青青青青草视频|
久久综合色鬼综合色|
又大又猛又粗国产精品|
日韩av在线www|
亚洲高清专区日韩精品|
韩国中出人妇免费观看|
亚洲成av人片高潮喷水漫画|
嘿咻视频在线观看欧美国产|
欧美激情在线观看第二页|
亚洲精品日本久久一区二区三区|
精品三级国产在线看|
日摸夜夜添夜夜添人妻|
91大神一区二区三区在线视频|
久久伦理精品一区二区三区|
久久精品国产亚洲网站|
日本电影寂寞的熟妇|
午夜福利在线观看国产精品|
男人的天堂av高清|
aaa女生草逼免费视频|
人人爱人人插人人射|
亚洲av成人变态久久精品|
日韩av在线资源站|
国产自产拍精品视频|
久久久91国产在线|
中文字幕一区二区人妻|
日本最新精品视频在线播放|
亚洲一区二区三区av中文字幕|
麻豆精品一级片播放|
av在线免费观看观看|
亚洲成人男人的天堂|
一级做a在线播放免费|
中文字幕在线综合视频|
亚洲日本国产精品高清|
国产AV一区二区三区天堂综合网|
中文字幕亚洲美女av|
又大又猛又粗国产精品|
2020亚洲天堂网|
99热官网在线精品|
亚洲欧美黄片在线观看|
久久久999国产精品成人|
日韩美女午夜免费视频|
精品国产18久久久久久依依影院
|
国产精品观看在线亚洲人成网|
中文字幕在线综合视频|
国产一区二区三区老熟女|
国产自产拍精品视频|
国产精品久久久久精品首页|
午夜福利国产精品|
99热国产在线播放|
亚洲天堂精品久久网站|
大屌骚逼视频初恋|
1区2区3区中文字幕在线|
熟女怡红院一区二区|
日本少妇被黑人粗大的猛烈进|
国产一区不卡自拍视频在线观看
|
久久青草精品视频免费|
大鸡巴操逼骚逼护士|
久久青草精品视频免费|
青青草久久爱大香蕉|
精品视频一区二区三区在线播|
国产又粗又黄又长又爽动漫|
91中文看片片成人|
欧美 日韩一区 二区 久久|
男女操逼抠逼射精|
久久久久久一级毛片高清|
美女主播操逼逼内射|
国产精品不卡在线观看的a站
|
五十路熟女一区二区视频|
一区二区三区精彩在线|
日韩欧美午夜福利视频|
国产黄色三级三级看三级|
人妻系列久久久精品|
久久久久一区精品网|
蜜臀久久精品久久久久酒店|
欧美激情丝袜一区二区三区|
日韩av在线www|
一区二区三区在线少妇|
啊啊啊啊啊好大好长好爽视频|
亚洲黄色电影四区欧洲|
俄罗斯美女熟妇69|
国产香蕉久久精品免费|
91久久精品国产成人|
美女大尺度自慰抠穴流白浆呻|
亚洲黄色免费av电影|
日韩久久精品五月综合|
色婷婷av电影在线|
高清黄片免费在线观看一区二区|
中文字幕巨大的乳专区二区|
操日本女人逼逼出水|
日韩av网一区二区三区四区|
午夜人妻精品福利视频|
久久这里只有精品蜜臀|
欧美日韩国产自拍成人|
波多野结衣中文先锋资源|
亚洲欧美激情国产一区二区|
97久久久久久国产精品|
看看大鸡巴操逼视频|
欧美日韩在线视频你懂的|
国产精品视频偷拍自拍|
久久久久久久久九热|
蜜桃一卡二卡在线观看|
国产h在线视频观看|
国产成人综合亚洲亚洲国产第一页|
免费在线观看的黄片视频在线观看|
五月婷婷六月色综合|
国产自产拍精品视频|
国产精品极品久久久|
女人18毛片a级毛片视频|
18国产精品成久久久久三级|
美女洗澡偷拍一区二区|
亚洲视频一区二区蜜桃|
9re精品视频在线观看|
在线被黑人操虚脱|
久久久久久久久久久9|
国产精品AV在线|
人妻av在线区一区二区三|
日韩午夜福利无码专区A|
亚洲毛片一区二区免费看|
五月婷婷激情综合av|
亚洲综合久久区二区三区|
五月婷婷丁香婷婷丁香国产|
日韩av在线www|
亚洲av免费在线网站|
男生操白丝袜美女逼逼|
婷婷五月花亚洲一区在线观看
|
曰韩无码中文字幕毛片一级|
操欧美肥胖女人大逼|
在办公室被c到高潮小雪|
欧美大屁股体内射精视频|
婷婷午夜美女诱惑福利电影网|
久热操视频精品在线观看|
国产盗摄精品一区二区三区|
中出少妇一区二区三区|
国产一区二区三区免费视频网站
|
五月婷婷激情综合少妇|
欧美激情视频在线观看|
成人免费福利视频一区|
精品久久久在线观看|
婷婷五月开心五月久久
|
在线播放婷婷激情五月天|
久久中文字幕亚洲三区|
久久热这里只有精品1|
国产老熟女视频一区|
久久久久久黄色精品视频|
手机看片日韩高清国产欧美|
国产精品AV在线|
亚洲iv一区二区三区|
人妻欲求不满av中文字幕一区|
国产精品国产三级国av麻豆|
国产男女乱婬真视频免费|
国产三级久久免费网|
性感美女脱内裤被打屁股|
国产精品久久久私一本|
午夜福利欧美激情国产|
日韩一二三区操逼视频|
国产麻豆一精品一av一免费|
中文字幕在线播放av|
国产日韩欧美视频二区|
一级做a在线播放免费|
大帝av一区二区三区|
日韩精品视频中文字幕|
美女午夜福利视频一区二区|
国产成人和好了品丝袜视频|
久久这里只有精品蜜臀|
中文字幕人妻森泽佳奈|
国产伦精品二区一区二区三区|
一道本一区二区三区不卡|
免费观看亚洲视频一区二区三区|
久久久成人免费av网站|
婷婷午夜美女诱惑福利电影网|
亚洲精品1区2区3区4|
日韩熟女在线第一页|
国产内射一级一片高清视频|
少妇性久久久久久久|
精品女同一区二区三区在线观看|
成人在线视频 国产|
色哟哟一区二区三区精品|
午夜福利国产精品|
精品久久久久久久久97|
无遮挡在线观看视频国产欧洲|
91精品麻豆国产自产在线播放|
久久这里只有精品久|
九九热免费视频精品在线观看|
色哟哟 欧美 日韩|
国产av一区二区三四区|
深田咏美无码资源在线观看|
人妻欲求不满av中文字幕一区|
男同gay18禁免费网站高清|
五月婷婷六月丁香av|
99久久草精品视频|
久碰人妻人妻人妻人|
久久天天做人妻人碰|
中文字幕人妻丝袜成熟一区|
9re精品视频在线观看|
欧美三级久久三级久久三级|
日本在线视频一区二区三区|
中文字幕人妻中出日本|
美国大吊操 视频直播间|
观看在线人成大全黄|
亚洲欧美 偷拍综合|
久久高清免费福利视频|
美女主播大奶子户外操逼尿尿|
国产成人高精品免费视频|
91大神在线观看一区二区三区|
日本大香蕉在线观看视频|
我要看国产精品毛片|
三级国产自拍在线观看|
国产电影精品久久久久久
|
AV无码精品一区二区三区宅噜噜|
男人av及亚洲天堂|
国产h在线视频观看|
日本一卡二卡三卡在线视频|
精品久久久久久久毛片|
久久热这里只有精品网|
欧美一区二区三区爽大粗|
国产九九九久久久久|
在线视频你懂得色日韩|
国产精品人妻免费看|
久久艹精品中文字幕|
中国亲子伦理一区二区|
成人18岁视频在线观看|
激情五月天小说婷婷|
天天摸夜夜操国产精品|
巨吊在线观看免费成人
|
成人免费全程视频在线观看|
午夜短视频福利在线播放|
快来插我的骚逼我好想要视频|
九九在线免费播放视频|
99re 久久这里只有精品首页|
91re视频免费看|
av中文字幕高清片|
国产色婷婷精品免费|
国产不卡视频一区二区|
精品久久久久久久久97|
99精品国自产在线|
老司机啪啪啪啪拍|
日本怡红院在线观看视频|
中文字幕人妻丝袜成熟一区|
色综合久久五月综合|
精品国产乱码久久久久桃花|
精品久久久久久久一区二区伦理|
亚洲午夜久久久久久69|
中文字幕永久精品国产|
欧美综合亚洲无女搜查官|
午夜福利视频日韩精品|
亚洲高清一区二区高清|
av午夜福利亚洲精品福利|
欧美 日韩一区 二区 久久|
蜜臀在线一区二区三区|
国产资源在线观看|
亚洲欧美人兽在线|
日本性感熟妇三级电影|
久久国产成人一区二区三区|
亚色视频在线观看|
国产av一区二区三四区|
丰满人妻一区二区三区站长|
韩日最新黄色激情片|
国产精品中文字幕久久|
美女喜欢大鸡巴日视频|
日本一二三区不卡在线|
在线中文字幕人妻一区一区|
99热国产这里只有金品|
双性恋大黑鸡吧大奶子视频日本|
五月婷婷中文字幕在线|
黑人性黄色大片免费看|
国产在线观看青青青|
国产二区三区在线播放|
久久毛片免费观看大全|
小舞自己扒开屁股让男人桶|
操死我了舒服免费视频|
99热99精品自拍|
骚穴大鸡巴在线视频|
久久毛片免费观看大全|
特黄aa完整性大片|
久久婷婷免费综合国产精品|
99久久国产亚洲精品美女|
精品影片丰满熟女亚洲欧洲区
|
欧美一级a一级a爱片免|
国产香蕉久久精品免费|
久久超级碰碰人妻人人妻|
国产主播一区二区三区在线
|
插逼男喷白浆视频|
国产色婷婷精品免费|
亚洲婷婷综合久久狠狠|
久久久国产精品成人免费视频|
亚洲精品国产成人版|
中文字幕永久乱码在线|
2023年国产免费看精品黄片|
久久婷婷免费综合国产精品|
中文婷婷四五月激情在线|
韩国中出人妇免费观看|
处女自拍视频色哟哟在线|
99久久国产亚洲精品美女|
玖玖爱在线免费视频|
99热99精品自拍|
又黄又爽又猛的视频免费|
日本一二三区不卡在线|
亚洲av免费在线网站|
国产欧美日韩另类视频在线观看|
视频三区视频一区视频二区|
一区二区三区爽视频|
搬开逼操喷水视频|
97人妻碰碰碰久久香蕉|
亚洲丰满少妇xxx高潮|
亚洲欧美日韩在线不卡中文|
日韩色在线观看视频
|
我不卡在线观看高清视频|
18禁无遮挡啪啪|
一区二区三区精彩在线|
嗯疼轻点视频免费观看视频|
国产自产拍精品视频|
精品97久久久久久|
久久这里只有精品小视频|
中文字幕成人免费视频|
黑人大吊摇进日本女人阴道|
亚洲黄色一区二区三区四区|
亚洲欧美另类国产第1页|
三级国产自拍在线观看|
人人妻人人搞人人插|
日韩欧美一级视频在线播放|
丝袜脚交一区二区三区精品|
深爱婷婷激情五月天|
故意挺着两个大骚奶头视频|
亚洲国产精品久久网午夜|
五月婷婷激情综合少妇|
日本中文字幕在视频|
日本一区二区三区四区啪啪啪
|
男生草女生在线看|
亚洲一区亚洲精品久久|
成年女人看片免费视频中文|
欧美一区二区三区精选|
精品久久久久久中字幕天码|
欧美日韩国产免费视频|
欧美日韩综合网久久精品|
婷婷午夜精品久久久久|
久久精品在这里999|
精品一区二区色呦呦|
欧美国精产品一二区|
美女亚洲熟妇www片毛片|
97人妻碰碰碰久久香蕉|
久久只有精品婷婷五月天尤
|
亚洲中文av中文字幕|
国产日产欧美一区二区在线观看|
午夜激情视频在线免费看|
91成人在线观看网|
中文字幕一区二区人妻|
制服丝袜中文字幕在线观看|
丰满少妇被猛烈进入一区二区|
99热久久精品国产|
国产精品免费观在线|
久久伊人综合大香蕉|
九九热九九热这里只有精品|
国产一区二区三区激情在线|
久久国产亚洲精品嫩草|
91成年人免费视频|
久久国产亚洲精品嫩草|
日韩中文字幕性视频|
男生操白丝袜美女逼逼|
婷婷婷婷婷婷婷婷色图|
久久久久精品国产色戒|
丰满人妻一区二区三区站长|
国产伦理一区二区在线|
国产亚洲无线码一区二区|
国产av一区二区三区中文|
日本99精品视频在线|
殴美女人久久久久18|
国产成人区在线观看|
一区二区三区精彩在线|
日韩专区一中文字目一区二区
|
国产极品av一区二区三区|
日韩大屁股在线一区二区|
久久欧美三级福利视频|
午夜福利激情视频在线观看|
真实嫖中年下岗妇女|
天天射天天插天天爱|
国产一区一一一区麻豆|
青娱乐福利在线观看|
国产人妻人人做人碰人人爽|
99热精品在线好的|
中文字幕亚洲丝袜美腿|
日本美女大屁股Bb爽死了|
人人妻人人澡人人妻人人澡人人
|
小黄片免费在线播放观看|
婷婷婷婷婷婷婷婷色图|
婷婷丁香五月天激情|
中国亲子伦理一区二区|
一区二区在线精品亚洲|
91熟女性高潮视频|
久久久久久国产99|
丰满人妻熟妇又伦精品软件|
深夜福利视频网站在线|
国产大陆久久久久久|
欧美成人午夜久久久|
亚洲情色 熟女人妻|
精品人妻少妇一区二三区四虎狼人|
91精品国产91次久久福利|
久久伦理精品一区二区三区|
捅女人骚逼视频软件|
www久久久com|
日韩中文字幕不卡视频|
偷拍日本美女操B操B尿尿|
91色视频东北熟女|
国产精品污一区二区三区在线观看
|
国产精品午夜精品视频|
伊人久久网伊人网综合网|
久久久久久久久熟女av|
日韩精品国产自拍在线|
国产精品一级毛片无精东影业|
激情五月天在线电影大全|
啊啊啊啊草逼视频|
亚洲精品97久久久|
国产农村妇女三级全黄在线阅读|
97精品久久久久免费观看|
日韩免费一级中文字幕视频
|
18国产精品成久久久久三级
|
日本性爱无遮挡视频|
91一区二区精品在线|
在线观看片a免费不卡观看|
色成人片免费下载|
中文字幕人妻丝袜av|
91大神完整在线观看|
亚洲国产精品成人av在线81|
久久久中文字幕av|
成人午夜啪视频在线|
亚洲国产综合偷拍自拍|
国产又粗又长又硬又爽|
亚洲av中文乱码乱人伦在线|
亚洲国产中文片论片在线播放|
成人一区二区三区免费在线观看|
深夜福利视频网站在线|
亚洲偷自拍拍综合网|
非洲大鸡巴日我免费视频|
91网精品啪啪影视|
97人妻一区二区精品视频|
亚洲av免费在线网站|
婷婷激情五月马上播出|
18禁无遮挡啪啪|
老司机一区二区三四区|
色综合伊人色综合网|
亚洲乱码av中文一区二区在线看
|
国产又大又粗的黄色三级片播放|
日韩一区二区三区无类别|
91香蕉鉴黄师污污|
人妻丝袜美腿中文字|
在线日韩一区二区三区四区|
男人操女人逼穴网站|
色哟哟网站国产精品|
黄色不卡的视频网站一区二区|
亚洲男人天堂 av|
九九九视频免费观看|
视频三区视频一区视频二区|
中文字幕丰满人妻熟女|
黑丝美女被操到爽在线观看|
亚洲中文字幕欧美中文字幕|
国产精品免费观在线|
国产精品精华液一区二区|
久久99都市激情五月|
久久久999国产精品成人|
欧美在线一区二区三区视频|
人妻少妇偷人精品久久人|
久久99热精品在线|
男生插白虎操逼视频|
中文字幕巨大的乳专区二区|
国产大尺度福利视频|
国产女人高潮嗷嗷叫视频|
插入女人逼逼视频|
亚洲精品成人在线免费观看|
黑丝美女被操到爽在线观看|
91在线看中文字幕|
被前后进入的熟妇羞辱|
亚洲国产精品美女电影|
久久久久久三级精品|
完整字幕勾引少妇久久|
国产小v视频在线播放观看|
插入女人逼逼视频|
大鸡巴操逼AV网|
亚洲中文字幕免费高清在线观看
|
99re 久久这里只有精品首页|
久久精品国产亚洲av麻豆一|
久久婷婷免费综合国产精品|
国产一区一一一区麻豆|
日韩美女精品视频在线观看网站|
在线日韩精品视频一区二区三区|
欧美一区二区三区二区|
久久伊人综合大香蕉|
99国内精品久久久久久久水蜜桃|
别刊91噜噜尤物写真|
四虎影视国产精品免费久久|
国产电影精品久久久久久|
亚洲一区二区久久久久久久|
亚洲一区二区女厕偷拍|
国产精品免费观在线|
大香蕉国产免费av|
国产毛片91最新在线看|
亚洲成人午夜精品av|
中文字幕一区二区天码视频|
美女被大鸡巴干了视频网站|
天天干天天艹一区二区|
久久精品国产免费观看|
99热国产精品re|
青娱乐一亚洲高清视频在线观看|
男人操妇女大红肉p|
亚洲三级一区在线观看|
波多野结衣中文先锋资源|
久久黄片在线免费观看|
欧美激情视频在线观看|
大鸡吧在线免费视频|
久久午夜夜伦鲁鲁影片|
粗大的内捧猛烈进出爽女视频|
成人午夜啪视频在线|
九色porny91|
韩国女人屁股插了根大棒子|
fc2国产精品视频|
美女13性爱视频鸡巴插进逼里|
亚洲欧美卡通制服丝袜|
中文字幕午夜av福利|
婷婷五月花亚洲一区在线观看|
国产久久久久久18|
欧美日韩精品亚洲专区|
人妻沦为恶霸性玩物|
91精品国产综合久久婷婷|
国产一区二区三区老熟女|
小黄片免费在线播放观看|
操日本女人逼逼出水|
免费看精品黄色视频|
久久99都市激情五月|
亚洲精品无码不卡久久久久纱香|
人人舔天天操人人射|
熟女怡红院一区二区|
91久久久久国产一区|
国产成人精品视频免|
久久热这里只有精品1|
日韩成人性视频网站|
久香蕉多久香蕉俺去也|
日韩久久精品五月综合|
国产精品黄色免费网站|
国产精品网站在线观看免费传媒|
欧美高清成人一区二区|
吃老师的黑鲍鱼喷白浆给我吃
|
成人国产av精品蜜桃小|
在线精品日韩亚洲欧一二三区|
精品一卡二卡三卡四卡兔|
亚洲一区二区女厕偷拍|
免费在线播放中文字幕|
久久精品国产色色|
2023年国产免费看精品黄片|
欧美大鸡巴操逼聊骚的视频|
日韩欧美午夜福利视频|
人妻沦为恶霸性玩物|
日中文字幕成人在线视频|
色成人片免费下载|
啊啊啊快点插逼视频|
美国大吊操 视频直播间|
1区2区3区中文字幕在线|
欧美日韩精品亚洲一区二区|
久久视频精品熟女一区二区|
久久婷婷视频在线观看|
亚洲免费一区二区视频|
丰满人妻一区二区三区站长|
麻豆精品一级片播放|
亚洲一区二区在线观看一区|
精品一区二区三区推荐|
91大神完整在线观看|
精品一区二区二区久久久久久|
亚洲最色在线视频观看|
久久热这里只有精品网|
精品国产视频免费看|
欧美亚洲综合另类色妞网|
美女被大鸡巴干了视频网站|
小舞自己扒开屁股让男人桶|
一区二区三区白浆喷水爆乳
|
日本乱一区二区三区|
免费99国产欧美另类久久久精品|
蜜臀av噜噜一区二区|
日韩亚洲国产精品一区|
日本最新一区二区三区电影|
99久草青青草天堂在线|
国产乱码精品久久久一区二区三区|
国产又粗又爽免费视频|
欧美国产日韩一区二区三区在线|
快来插我的骚逼我好想要视频|
麻豆天美传媒在线观看|
亚洲一卡二卡三卡四卡精品|
亚洲美女在线观看福利视频网站|
高潮按摩久久久久久av免费|
亚洲黄色一级高清视频|
日韩人妻av大片网|
久久精品这里精品6|
伊人久久成人综合网|
99国产熟女高清久久久久久|
五月婷婷激情综合少妇|
国语对白三级在线观看|
欧美日韩亚洲国产综合在线观看|
国产亚洲欧美91极品|
中文字幕丰满乱子无码视频
|
十几根大鸡巴操小骚逼视频
|
粉嫩欧美一区二区三区|
别刊91噜噜尤物写真|
中文字幕人妻熟女二区|
大奶子成人直播伦理视频播放|
国产精品视频 射精|
91亚色网站在线观看|
五月激情婷婷丁香综合基地|
在线观看蜜桃一卡二卡|
日韩欧美美女在线视频|
国产精品午夜免费福利|
欧美一区二区三区爽大粗视频|
亚洲国产精品wwww|
国产免费一区二区在线视频|
六七十路熟女交尾五十路播放|
亚洲精品97久久久|
最近中文字幕无吗免费视频|
粉嫩欧美一区二区三区|
久久国产亚洲精选av|
欧美日韩久久17c|
国产自拍 在线视频|
国产黄色大片一区二区|
在线精品日韩亚洲欧一二三区|
国产久久久中文字幕|
亚洲欧洲综合分析在线|
国产色频一二区亚洲|
亚洲岛国一区二区三区|
亚洲伊甸园久久伊人久久|
丰满人妻丝袜制服中出|
日本女人一区二区三区国产欧美|
青草精品视频在线中文字幕|
国内精品久久久久精品不卡|
亚洲无码在线观看第一页|
五十路熟女一区二区视频|
97精品人妻一区二区|
亚洲国产精品成人综合久久|
国产精品久久色av|
啊啊啊好爽使劲插视频|
欧美日韩中文精品一本通|
日韩一区二区黄色网|
亚洲av成人变态久久精品
|
日本野外强奷在线播放va|
韩日精品一区二区三区|
欧美日韩三级伦理片|
成人看片18女人毛片免费看|
97精品国产高清在线看|
国产久久久久久18|
黄色激情一区二区三区|
国产一区二三区好的|
久久精品 国产精品|
成人不卡中文字幕一区二区|
偷拍熟女精彩对白91九色|
用大鸡巴操美女屁股视频|
北条麻妃亚洲一区二区在线|
亚洲嫩模喷白浆在线观看自拍
|
精品国产99久久久久久久久|
婷婷综合中文字幕在线|
黄色污污污网站在线|
激情五月天在线电影大全|
国产精品久久一区中出喷水|
熟女掰开自己阴道让男人插视频|
91精品 一区二区|
日本大香蕉在线观看视频|
婷婷五月花亚洲一区在线观看|
国产精品,在线播放|
欧美日韩一区在线观看亚洲|
高清黄片免费在线观看一区二区|
成人专区污污污污污污网|
日本少妇高清一区二区蜜桃|
亚洲天堂男人2023|
中文字幕一区三区四区|
国产不卡视频一区二区|
免费AV在线观看|
久久亚洲精品视频|
亚洲人妻我在线视频|
日本一卡二卡三卡在线视频|
天天舔天天插天天干|
777在线视频免费观看|
深夜福利免费看片网站|
精品999中文视频|
五月天青青草亚洲精品|
日韩免费在线精品视频|
激情片段一区二区三区|
天堂午夜不卡一区二区|
91自拍视频在线看|
一区二区三区嗯嗯啊啊|
日韩美女午夜免费视频|
美女13性爱视频鸡巴插进逼里|
完整字幕勾引少妇久久|
国产精品视频在视频|
国产成?人?综合?亚洲网站|
阴茎猛插阴道视频|
欧美久久久精品久久久精品|
久久久久国产精品免费|
国产一区二区黄页网站|
成人欧美一区二区三区蜜臀|
最新中文字幕av在|
向井蓝被黑人中出的人妻|
97国产在线一区二区精品|
亚洲国产精品一区二区三区av|
人妻夜夜爽天天爽爽|
日本一二三区不卡在线|
东北骚逼女人操逼对白大片|
久久精品国产免费观看|
日韩午夜福利无码专区A|
国产av一区二区三四区|
亚洲欧美久久精品18禁|
骚穴大鸡巴在线视频|
色综合久久久久粉嫩|
99久久久久久精品|
男女深喉偷拍视频一区二区三区
|
亚洲国产精品成人综合久久|
操日本女人逼逼出水|
日本不卡在线视频你懂的|
国产一区二区三区免费视频网站
|
91欧洲午夜精品久久久久|
大胆gogo人体无码免费视频|
亚洲美女国产精品久久|
亚洲激情制服诱惑网|
久久精品人人妻人人澡|
热99re久久精品天堂vr|
亚洲日本国产精品高清|
日本不卡一二三区高清视频|
国产一区二区麻豆视频|
综合欧美一区 二区 三区|
日韩欧美在线视频|
国产一区二区三区激情在线|
毛片免费久久蜜臀av|
黄色污污污网站在线|
国产精品视频在视频|
久久五月七月综合激情夜|
91久久精品国产成人|
在线日韩一区二区三区四区|
亚洲欧美卡通制服丝袜|
国产欧美一区二区久久久|
亚洲另类综合图片小说|
av在线免费观看观看|
欧美激情丝袜一区二区三区|
久久久久国产精品免费|
国产亚洲精品福利在线无卡一|
黑森林精选av导航|
日本电影寂寞的熟妇|
国内精品久久久久精品不卡|
欧美在线第一日韩视频|
国产亚洲精品福利在线无卡一|
久久热这里只有精品1|
国产一区不卡自拍视频在线观看
|
久久黄片久久毛片久久|
亚洲美女自拍偷拍视频|
欧美一区二区三区在|
人人妻免费在线视频|
欧美一级a一级a爱片免|
久久婷五月天色综合久久|
老熟女偷拍一区二区|
欧美寡妇性生活一区二区三区|
久久久999国产在线|
嗯嗯啊啊啊啊好紧视频|
在线日韩一区二区三区四区|
91熟女性高潮视频|
91超碰在线欧美人|
国产一级特黄aaa片做|
最近91中文字幕二区|
中文字幕亚洲欧美日韩高清|
天天插天天透大香蕉伊人|
亚洲av不卡观看入口|
蜜芽忘忧草三区老狼大豆|
一区二区三区日韩免费观看97|
色哟哟免费观看网站|
日韩区中文字幕在线观看|
欧美日韩久久综合网|
偷窥亚州欧美自拍另类|
99久久久久久精品|
高级亚洲成人色情网站|
国产麻豆一精品一av一免费|
色婷婷福利视频网站|
又大又粗叽叽插BB视频|
91香蕉鉴黄师污污|
中文字幕高清国产av|
激情五月天小说婷婷|
亚洲毛片一区二区免费看|
国产目拍亚洲精品一区二区三区|
人人躁这里只有精品|
红桃一区二区三区在线|
色婷婷一区二区三区啪啪|
欧美一级福利视频|
婷婷综合中文字幕在线|
动态女潮吹黑人色欲|
男人插女人的b视频|
91精品92久久久|
久久热这里只有精品网|
91久久精品国产成人|
天天射天天干天天插|
人人爱人人插人人射|
久久香蕉av天堂第一|
色99热久久99热国产精品|
爽歪歪视频在线观看|
1区2区3区中文字幕在线|
亚洲欧美激情国产一区二区|
色女av一区二区三区|
久久这里只有精品小视频|
欧美一区二区三区在|
日韩免费在线精品视频|
国产日韩欧美性生活|
国产精品卡一卡二卡三卡四|
最近中文字幕高mv在线|
国产一区不卡自拍视频在线观看|
91在线521欧美|
亚洲欧美成人av电影|
好看的国产精品视频|
国产一区二区黄页网站|
偷窥亚州欧美自拍另类|
国产91色免费在线|
激情片段一区二区三区|
成人精品一区二区三区免费|
日韩中文字幕不卡视频|
午夜人妻网址中文字幕|
蜜桃av免费精品一区二区|
亚洲成人精品久久91|
入口一区二区三区国产|
午夜福利欧美激情国产|
中文字幕乱码亚洲无线|
国内精品一区二区三区在线视频
|
美味人妻2016韩国电影|
亚洲国产精品wwww|
美女吃大机巴被美国人操|
成人国产精品原创在线观看|
大香蕉久久一本网站|
亚洲美女自拍偷拍视频|
亚洲色图第一页在线观看|
女人18毛片a级毛片视频|
国产精品国产亚洲区艳妇系列短篇
|
男人的天堂VA在线无码|
欧美一区二区三区在|
大屌骚逼视频初恋|
中文字幕丰满乱子无码视频|
69色在线观看视频|
婷婷五月开心五月久久
|
亚欧美日韩一区二区三区|
久香蕉多久香蕉俺去也|
人妻系日韩AV无码|
热99re久久精品天堂vr|
亚洲综合在线蜜臀av|
国产盗摄一区二区三区在线|
女生黑骚逼被操高潮视频|
亚洲欧美黄片在线观看|
国产精品一区二区三区熟女|
久久久成国产人精品|
美女吃大机巴被美国人操|
丰满人妻丝袜制服中出|
久久99综合久久久久|
爆操美女的逼黄片|
韩国久久久久三级成人|
亚洲另类激情另类图片|
国产av自拍偷拍网|
精品久久久久久久久久人妻热|
久久久久久久久久久久久79|
久久精品这里精品6|
亚洲精品国产精品成人不卡|
日韩av免费观看一区日日骚|
制丝袜业一区二区三区|
五月婷婷高清在线观看|
欧美日韩亚洲国产综合在线观看|
91热爆按摩偷拍|
色哟哟免费观看网站|
干了个少妇水好多视频|
中文字幕人妻中出在线播放|
亚洲一卡二卡三卡四卡精品|
99久热只有精品视频免费看|
啊啊啊不要我受不了了|
国产三级久久免费网|
久碰人妻人妻人妻人|
巨乳人妻视频中文字幕|
国产精品第一页在线|
国产熟女自拍视频免费看|
尻日本女人的大逼|
欧美一区二区三区四区动漫|
大鸡巴操逼AV网|
亚洲精品不卡久久久|
亚洲最色在线视频观看|
一区二区三区亚洲情色|
91香蕉鉴黄师污污|
国产精品视频在视频|
欧美激情丝袜一区二区三区|
制丝袜业一区二区三区|
最近中文字幕高mv在线|
美女乳头视频一区二区|
国产成人亚洲综合一区二区三区
|
五月婷婷青青草视频一区二区三区|
波多野结衣在线成人精品|
一级毛片在线视频|
非洲大鸡巴日我免费视频|
夜夜春国产精品不卡一区二区|
久久日韩制服丝袜人妻|
成人国产av精品在|
精品久久久久久久毛片|
中文字幕乱码在线日韩|
日韩最新一级精品在线视频|
一区二区在线精品亚洲|
免费国产又色又爽又黄的视频|
国产一区二区在线综合在线|
97久久草精品视频|
男女深喉偷拍视频一区二区三区|
日本精品一区二区三区乱码|
欧美一区二区三区做受片|
中文字幕av资源一区|
亚洲久久夜色成人69|
十八款禁止看尿口入口|
成人亚洲欧美久久久久|
丰满美女午夜性开放av|
好看的中文字幕视频|
久久久久精品国产色戒|
久久爽中文字幕资源|
四十路六十路五十路熟妇|
亚洲天堂丰满人妻av|
伊人网免费在线观看高清版|
久久精品国产色色|
男人操女人逼穴网站|
色哟哟一区二区三区精品|
性感美女脱内裤被打屁股|
久久久少妇av电影|
91精品国产综合久久久久久蜜桃|
中文字幕永久精品国产|
日韩专区一中文字目一区二区|
好看的国产三级在线观看|
九九视频这里真的有精品视频|
亚欧美日韩一区二区三区|
亚洲精品国产成人版|
51男人天堂久久久|
最新中文字幕日本久久久|
国产精品卡一卡二卡三卡四|
国产成?人?综合?亚洲网站|
国产在线观看青青青|
久久久久久亚洲欧美|
操欧美肥胖女人大逼|
一区二区三精品人妻|
中文字幕乱码亚洲无线|
天堂午夜不卡一区二区|
av天堂 亚洲av|
久久久久综合8888|
吃老师的黑鲍鱼喷白浆给我吃
|
五月天精品一区二区|
亚洲国产精品美女电影|
午夜啪啪啪免费网站|
91人人妻人人澡人人精品|
国产18禁精品亚洲|
小黄片免费在线播放观看|
日本电影寂寞的熟妇|
亚洲一区 二区 精品|
丰满老熟女一区二区|
日韩不卡的av在线|
夜夜春国产精品不卡一区二区|
AV无码精品一区二区三区宅噜噜|
操欧美肥胖女人大逼|
人人妻人人搞人人插|
亚洲男人的天堂你懂的|
无遮挡粉嫩小泬自慰|
亚洲中文视频在线中文视频|
蜜桃视频网站在线观看|
91久久国产综合网|
人妻少妇偷人精品久久人|
国产精品,在线观看|
亚洲一区二区 在线看|
女人扒开尿道让男人捅|
久久精品在线视频观看|
成人国产一区二区在线看|
亚洲无码一区二区三区91|
美味人妻2016韩国电影|
一本色道久久综合中文字幕|
丰满人妻一区二区三区站长|
亚洲成人黄色av一区二区|
91久久国产综合网|
美女喜欢大鸡巴日视频|
国产极品粉嫩福利姬萌白酱|
乱熟女伦熟女的网站|
爽歪歪视频在线观看|
五月婷婷丁香六月基地|
av中文字幕高清片|
老头插老头大鸡一区|
999久久精品久久|
久久久久久久久久片|
久久精品综合网懂色|
国内精品久久久久精品不卡|
在线被黑人操虚脱|
91色精品在线播放|
中文字幕精品一区推荐|
亚洲av国产精品一区二区三区|
国产又粗又黄又长又爽动漫|
日韩综合网在线一区|
黑丝白虎高潮喷水|
色婷婷狠狠18禁久久久久|
色婷婷精品久久久久久久|
成人区人妻精品一|
亚洲中文字幕免费高清在线观看|
在线日韩精品视频一区二区三区|
国产精品精华液一区二区|
精品白丝国产在线观看|
五十路熟女一区二区视频|
亚洲一区二区丝袜美腿人妻|
开心 激情 五月天|
乱熟女伦熟女的网站|
91国高清视频在线|
大鸡吧操日本女人小逼视频看看|
五月天狠狠干狠狠操|
色综合久久五月综合|
深夜福利国产一区二区|
波多野结衣中文先锋资源|
91秘一区二区三区四区|
国产在线观看青青青|
伊人久久综合热线大杳蕉av|
亚洲欧美三级中文字幕|
欧美a级毛欧美1级a大片99|
亚洲男人天堂一区二区在线观看|
初撮六十路人妻五十路中出
|
亚洲欧美久久精品18禁|
91久久久视频在线观看|
欧美成人三级国产精品电影|
97精品人妻一区二区|
欧美一区二区三区二区|
老司机一区二区三四区|
久久cao在线观看|
中文婷婷四五月激情在线|
日韩一二三区操逼视频|
日韩欧美特级特黄大片|
国产av夏晴子黑人|
国产精品不卡av在线|
日韩人妻大奶子生活片|
色综合久久超碰色婷婷|
美味人妻2016韩国电影|
大鸡巴操逼AV网|
亚洲高清一区二区三区免费|
国产人妻麻豆蜜桃色|
日本高清不卡视频一区|
亚洲国产成人91久久精品|
天堂av蜜桃auv|
精品影片丰满熟女亚洲欧洲区
|
久久香蕉av天堂第一|
久久久少妇av电影|
午夜福利卫生纸福利院|
亚洲欧美 日韩在线|
揉搓摸捏乳舔插视频|
久久伦理精品一区二区三区|
日本午夜免费观看视频|
中文字幕人妻森泽佳奈|
久久爱爱视频免费看|
国产精品国产三级国av麻豆|
美女13性爱视频鸡巴插进逼里|
亚洲国产精品久久网午夜
|
五月婷婷丁香六月基地|
精品国产乱码久久久久区2区|
国产成人和好了品丝袜视频|
欧美一区二区三区爽大粗视频|
97国产在线一区二区精品|
国产偷国产偷亚洲视频|
男男调教后菊撑开扩张A片|
欧洲成人一区二区精视频|
亚洲伊甸园久久伊人久久|
午夜精品一区二区三区可下载|
亚洲欧美人兽在线|
欧美精品亚洲精品一区|
欧美日韩国产高清一区二区三区|
交换配乱吟粗大交换大叫视频|
久久日韩制服丝袜人妻|
中文字幕手机在线香蕉|
高清黄片免费在线观看一区二区|
国产18禁精品亚洲|
精品又大又粗又硬黄色偷拍|
中文字幕人妻丝袜成熟一区|
中文字幕亚洲精品小说|
欧美激情在线观看第二页|
大鸡吧操骚逼国外|
久久99精品国产一区二区影片|
精品久久久久人妻热|
可以在线看的av网址|
亚洲福利夜色在线视频|
免费久久久国产精品|
粗壮挺进邻居少妇的身体|
色婷婷av电影在线|
国产偷人妻精品一二三|
亚洲天堂欧美天堂淫人天堂|
97人人爽人人妻人人澡|
熟女人妇熟妇视频系列|
日骚逼内射免费视频|
日韩久久精品五月综合|
国产精品一区二区三区熟女|
国产欧美日韩综合精品一区二区|
欧美激情超碰在线免费|
91大神完整在线观看|
91亚洲日韩一区二区|
韩日最新黄色激情片|
91亚洲日韩一区二区|
漫画18禁无遮挡型略|
999精品在线视频|
透处女的免费视频|
在线观看911精品国产|
久久婷婷国产综合九月|
久久超级碰碰人妻人人妻
|
中文字幕人妻森泽佳奈|
亚洲日本中文字幕在线四区|
日本美女大屁股Bb爽死了|
国产青娱乐在线视频|
欧洲亚洲精品视频在线观看|
91成人在线观看网|
色的伦乱视频中文字幕|
韩国日本国产三级视频|
亲胸摸下面刺激视频|
中文字幕成人免费视频|
久久99国产精品99久久老牛|
亚洲久久夜色成人69|
婷婷午夜精品久久久久|
午夜亚洲AV永久无码精品|
亚洲另类激情另类图片|
国产18成人三级在线观看|
国产麻豆久久久久久久精品|
日韩欧美黄网站免费看|
日本福利片国产午夜久久|
婷婷午夜美女诱惑福利电影网|
中文字幕a区一区二区|
日韩av天堂手机在线观看|
中文字幕日韩欧美人妻|
91成人免费短视频|
十几根大鸡巴操小骚逼视频|
高跟丝袜熟女av一区二区三区|
精品国产欧美精品v|
国产69色在线视频|
国产成人综合亚洲亚洲国产第一页|
又黄又爽又猛的视频免费|
精品久久久久久久一区二区伦理|
大屌骚逼视频初恋|
亚洲一区二区 av|
国产日韩精品欧美综合区|
日韩精品视频中文字幕|
婷婷丁香九月天综合|
亚洲丰满少妇xxx高潮|
国产乱国产乱老熟300网址|
99国产精品久久久久久成人热|
av中文字幕18p|
精品一区二区三区不卡少妇|
日韩人妻av大片网|
日本最新精品视频在线播放|
一区二区三四区av|
国产精品一区二区三区熟女|
欧美激情在线一区二区|
中文字幕人妻森泽佳奈|
91色老久久久蜜臀|
国产青娱乐在线视频|
欧美日韩亚洲国产综合在线观看|
亚洲激情欧美日韩片|
亚洲av国产精品一区二区三区|
色综合久久久久粉嫩|
久久久久久久久久片|
嗯嗯啊啊啊成人在线观看视频|
av男人的天堂在线一区二区|
欧美中文字幕一区二区综合|
五月婷婷大香蕉综合|
亲胸摸下面刺激视频|
真人直播 免费视频|
大鸡巴操逼骚逼护士|
日韩成人性生活免费视频|
小雪好紧好滑好湿好爽在线观看|
老头插老头大鸡一区|
蜜桃久久久久久av|
韩国女人屁股插了根大棒子|
观看在线人成大全黄|
丰满人妻一区二区二区|
久久久久区二区国产|
欧美777精品久久久久网|
插逼视频免费看透女人逼|
国产精品,在线观看|
人妻中文佐佐木希字幕|
看欧美日韩女人日小B的|
99热毛片中文字幕|
中文字幕巨大的乳专区二区|
亚洲精品一区二区三区蜜桃下载|
欧美久久久精品久久久精品|
国产精品久久久久一级app|
国产精品黄片久久久久|
玖玖爱在线免费视频|
亚洲无码精品一区二区三区|
91精品国产综合久久久久久蜜桃|
美国一区二区免费视频|
天天射天天干天天插|
深田咏美无码资源在线观看|
日韩免费av在线一区二区三区|
激情五月天小说婷婷|
久久伊人成人免费网站|
日韩国产一区二区三区在线播放|
欧美成人三级国产精品电影|
男女深喉偷拍视频一区二区三区|
啊啊啊啊草逼视频|
亚洲欧美精品一区二区|
亚洲国产91精品国自产拍|
日韩激情av一区二区三区|
女人裸体无遮挡18禁止|
欧美日韩精品福利欧美|
经典三级开心五月天|
中文字幕一区二区天码视频|
蜜桃视频网站在线观看|
国产一区不卡自拍视频在线观看|
亚洲午夜久久久久久69|
亚洲国产色图图视频|
色女av一区二区三区|
丝袜美腿诱惑一区二区亚洲|
成人在线播放 自拍|
日本午夜免费观看视频|
日本黄色国产草逼视频|
国产亚洲精品久久久美女网站|
中文字幕亚洲美女av|
久久综合,久久综合|
一区二区三区爽视频|
用大鸡巴操美女屁股视频|
玖玖热国产在线观看|
男女男精品视频在线播放网站|
蜜臀在线一区二区三区|
欧美粉嫩一区二区三区婷婷|
美女亚洲熟妇www片毛片|
国内偷拍视频免费久久|
国产一区二区麻豆视频|
国产人妻人人做人碰人人爽|
91久久久视频在线观看|
国产极品av一区二区三区|
亚洲精品日韩精品日韩|
美女激情高潮久久黄色|
成年女人看片免费视频中文|
亚洲av成人变态久久精品|
亚洲天堂网最新网址|
真人直播 免费视频|
蜜桃一卡二卡在线观看|
搜索美女上厕所看逼逼|
爆操美女的逼黄片|
伊人久久大香蕉在线|
91超碰在线欧美人|
中文字幕国产不卡一区|
亚洲黄色电影四区欧洲|
国产又粗又黄又长又爽动漫|
四十路六十路五十路熟妇|
AV无码AV天天AV天天爽|
美女洗澡偷拍一区二区|
色成人片免费下载|
亚洲国产二区三区天堂|
国内av一区二区三区|
丝袜脚交一区二区三区精品|
欧美激情视频在线观看|
国产黄色三级三级看三级|
亚洲男人天堂视频在线|
国产精品一级二级三级视频|
熟女乱亚洲图丝袜美腿|
从后面抱住使劲日逼视频|
中文字幕巨大的乳专区二区|
人人妻人人妻人人18|
久久一区二区视频免费|
高清大学生毛片一级|
国产女主播福利在线播放|
九九热在线精品视频店|
日韩精品国产一二三区|
不卡av免费在线网址|
超清无码无码区无码一区|
国产精品国产三级在线高清观看|
中文字幕亚洲精品影院|
亚洲成人av电影播放
|
最新深夜男女福利片视频|
肥熟女巨臀一区二区三区|
日韩欧美一级性大片|
日本高清不卡视频一区|
亚洲av日韩av卡二|
日韩一区二区黄色网|